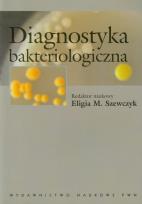
Opakowanie Diagnostyka bakteriologiczna

- Regulamin
- Koszty dostawy
- Kontakt
- Dziś w ofercie 243 952 produkty
KSIĄŻKI
- Albumy
- Beletrystyka
- Biografie
- Dla dzieci i młodzieży
- Edukacja
- Ekonomia i biznes
- Ezoteryka
- Historia
- Informatyka
- Kalendarze
- Komiksy
- Kryminał i sensacja
- Kultura i sztuka
- Literatura faktu
- Literatura kobieca
- Literatura piękna
- Medycyna
- Nauka języków obcych
- Nauki humanistyczne
- Nauki przyrodnicze
- Nauki ścisłe
- Podręczniki
- Poradniki
- Prawo i administracja
- Przewodniki i podróże
- Psychologia
- Religia
- Sport
- Technika
- Zdrowie i uroda
ZABAWKI
- Artykuły dla niemowląt
- Bączki
- Bujaki i skoczki
- Ciągnij / pchaj
- Dla niemowlaka
- Grzechotki i gryzaki
- Karuzele i pozytywki
- Maty i centra zabaw
- Projektory i lampki
- Sortery i piramidki
- Zabawki
- Edukacyjne i kreatywne
- Figurki
- Klocki
- Lalki
- Pojazdy
- Pluszaki i maskotki
- Sport i rekreacja
- Zabawa w dom
- Zabawki drewniane
- Puzzle
- Do 200 elementów
- 201-500 elementów
- 501-1000 elementów
- Ponad 1000 elementów
- Puzzle 3D
ART. PAP
- Artykuły biurowe
- Artykuły piśmiennicze
- Bloczki i kartki samoprzylepne
- Dziurkacze
- Kalkulatory
- Nożyczki i nożyki
- Skoroszyty
- Teczki
- Wizytowniki
- Zszywacze
- Artykuły szkolne
- Akcesoria szkolne
- Modelowanie
- Notatniki i zeszyty
- Piórniki
- Plecaki i torby
- Pojemniki na śniadanie
- Pomoce naukowe
- Przybory matematyczne
- Przybory rysunkowe
- Upominki i gadżety
- Akcesoria do książek
- Artykuły balowe
- Breloki i zawieszki
- Drobiazgi, różności
- Kubki
- Oferta Świąteczna
- Papeteria, kartki i naklejki
- Skarpetki Many Mornings
- Upominki
GRY
MULTIMEDIA
- Audiobooki
- Beletrystyka
- Biografie i wspomnienia
- Dla dzieci i młodzieży
- Fantastyka
- Filozofia i religia
- Historia
- Literatura faktu i reportaż
- Poradniki
- Sensacja i kryminał
- Filmy DVD/BD
- Animowane
- Biograficzne
- Fantasy
- Horrory
- Komedie
- Romanse
- Science Fiction
- Sensacyjne / kino akcji
- Thrillery
- Muzyka CD
- Alternatywna
- Blues
- Dla dzieci
- Jazz
- Klasyczna
- Piosenka aktorska i poetycka
- Pop
- Rock
- Świąteczna i kolędy
- Akcesoria GSM
- Głośniki
- Kable i adaptery
- Klawiatury
- Myszy
- Słuchawki
PROMOCJE
ZDROWIE
LEGO
- multiszop.pl \
- KSIĄŻKI \
- Medycyna \
- Jednostki chorobowe
Jednostki chorobowe
Wszystkie książki i multimedia z kategorii: Jednostki chorobowe dostępne w naszej ofercie z dużymi rabatami i w atrakcyjnych cenach. Książki specjalistyczne poruszające tematy schorzeń, chorób rzadkich, oraz leczenia. Propozycje książkowe dla studentów medycyny oraz lekarzy pracujących w zawodzie. Wiele podręczników oraz atlasów przydatnych podczas pracy. Zapraszamy do zapoznania się z naszą ofertą specjalistycznych książek, również z wielu innych dziedzin medycyny..
Uwaga!!!
Ten produkt jest zapowiedzią. Realizacja Twojego zamówienia ulegnie przez to wydłużeniu do czasu premiery tej pozycji. Czy chcesz dodać ten produkt do koszyka?


Wybierz wariant produktu